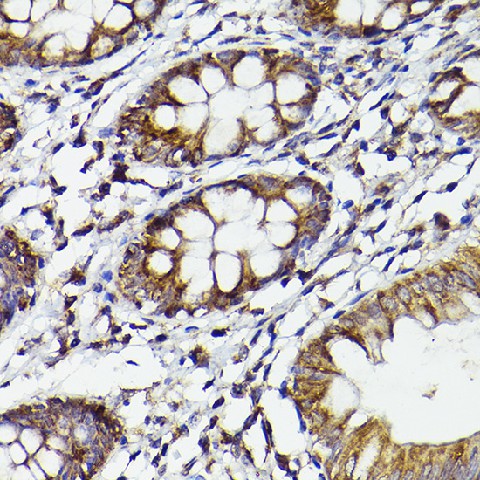
Валидация Elabscience E-AB-68287

Назначение
поликлональное антитело от производителя Elabscience к Prostaglandin Endoperoxide Synthase 2 (PTGS2) источник — кролик предназначено для детекции целевого антигена в биологических образцах. Продукт характеризуется подтвержденной реактивностью к человек, мышь, крыса.
Преимущества
- Высокая специфичность и аффинность
- Концентрация: 1 мг/мл
- Оптимизированный состав буфера: PBS с 0.05% Proclin-300,50% глицерин,pH7.3
- Стабильность: 12 месяцев
Применение в исследованиях
Условия хранения
Срок годности: 12 месяцев. Хранить при -20°C - 12 месяцев. Избегать повторяющихся циклов замораживания/оттаивания. Рекомендуется соблюдать температурный режим при транспортировке и хранении.